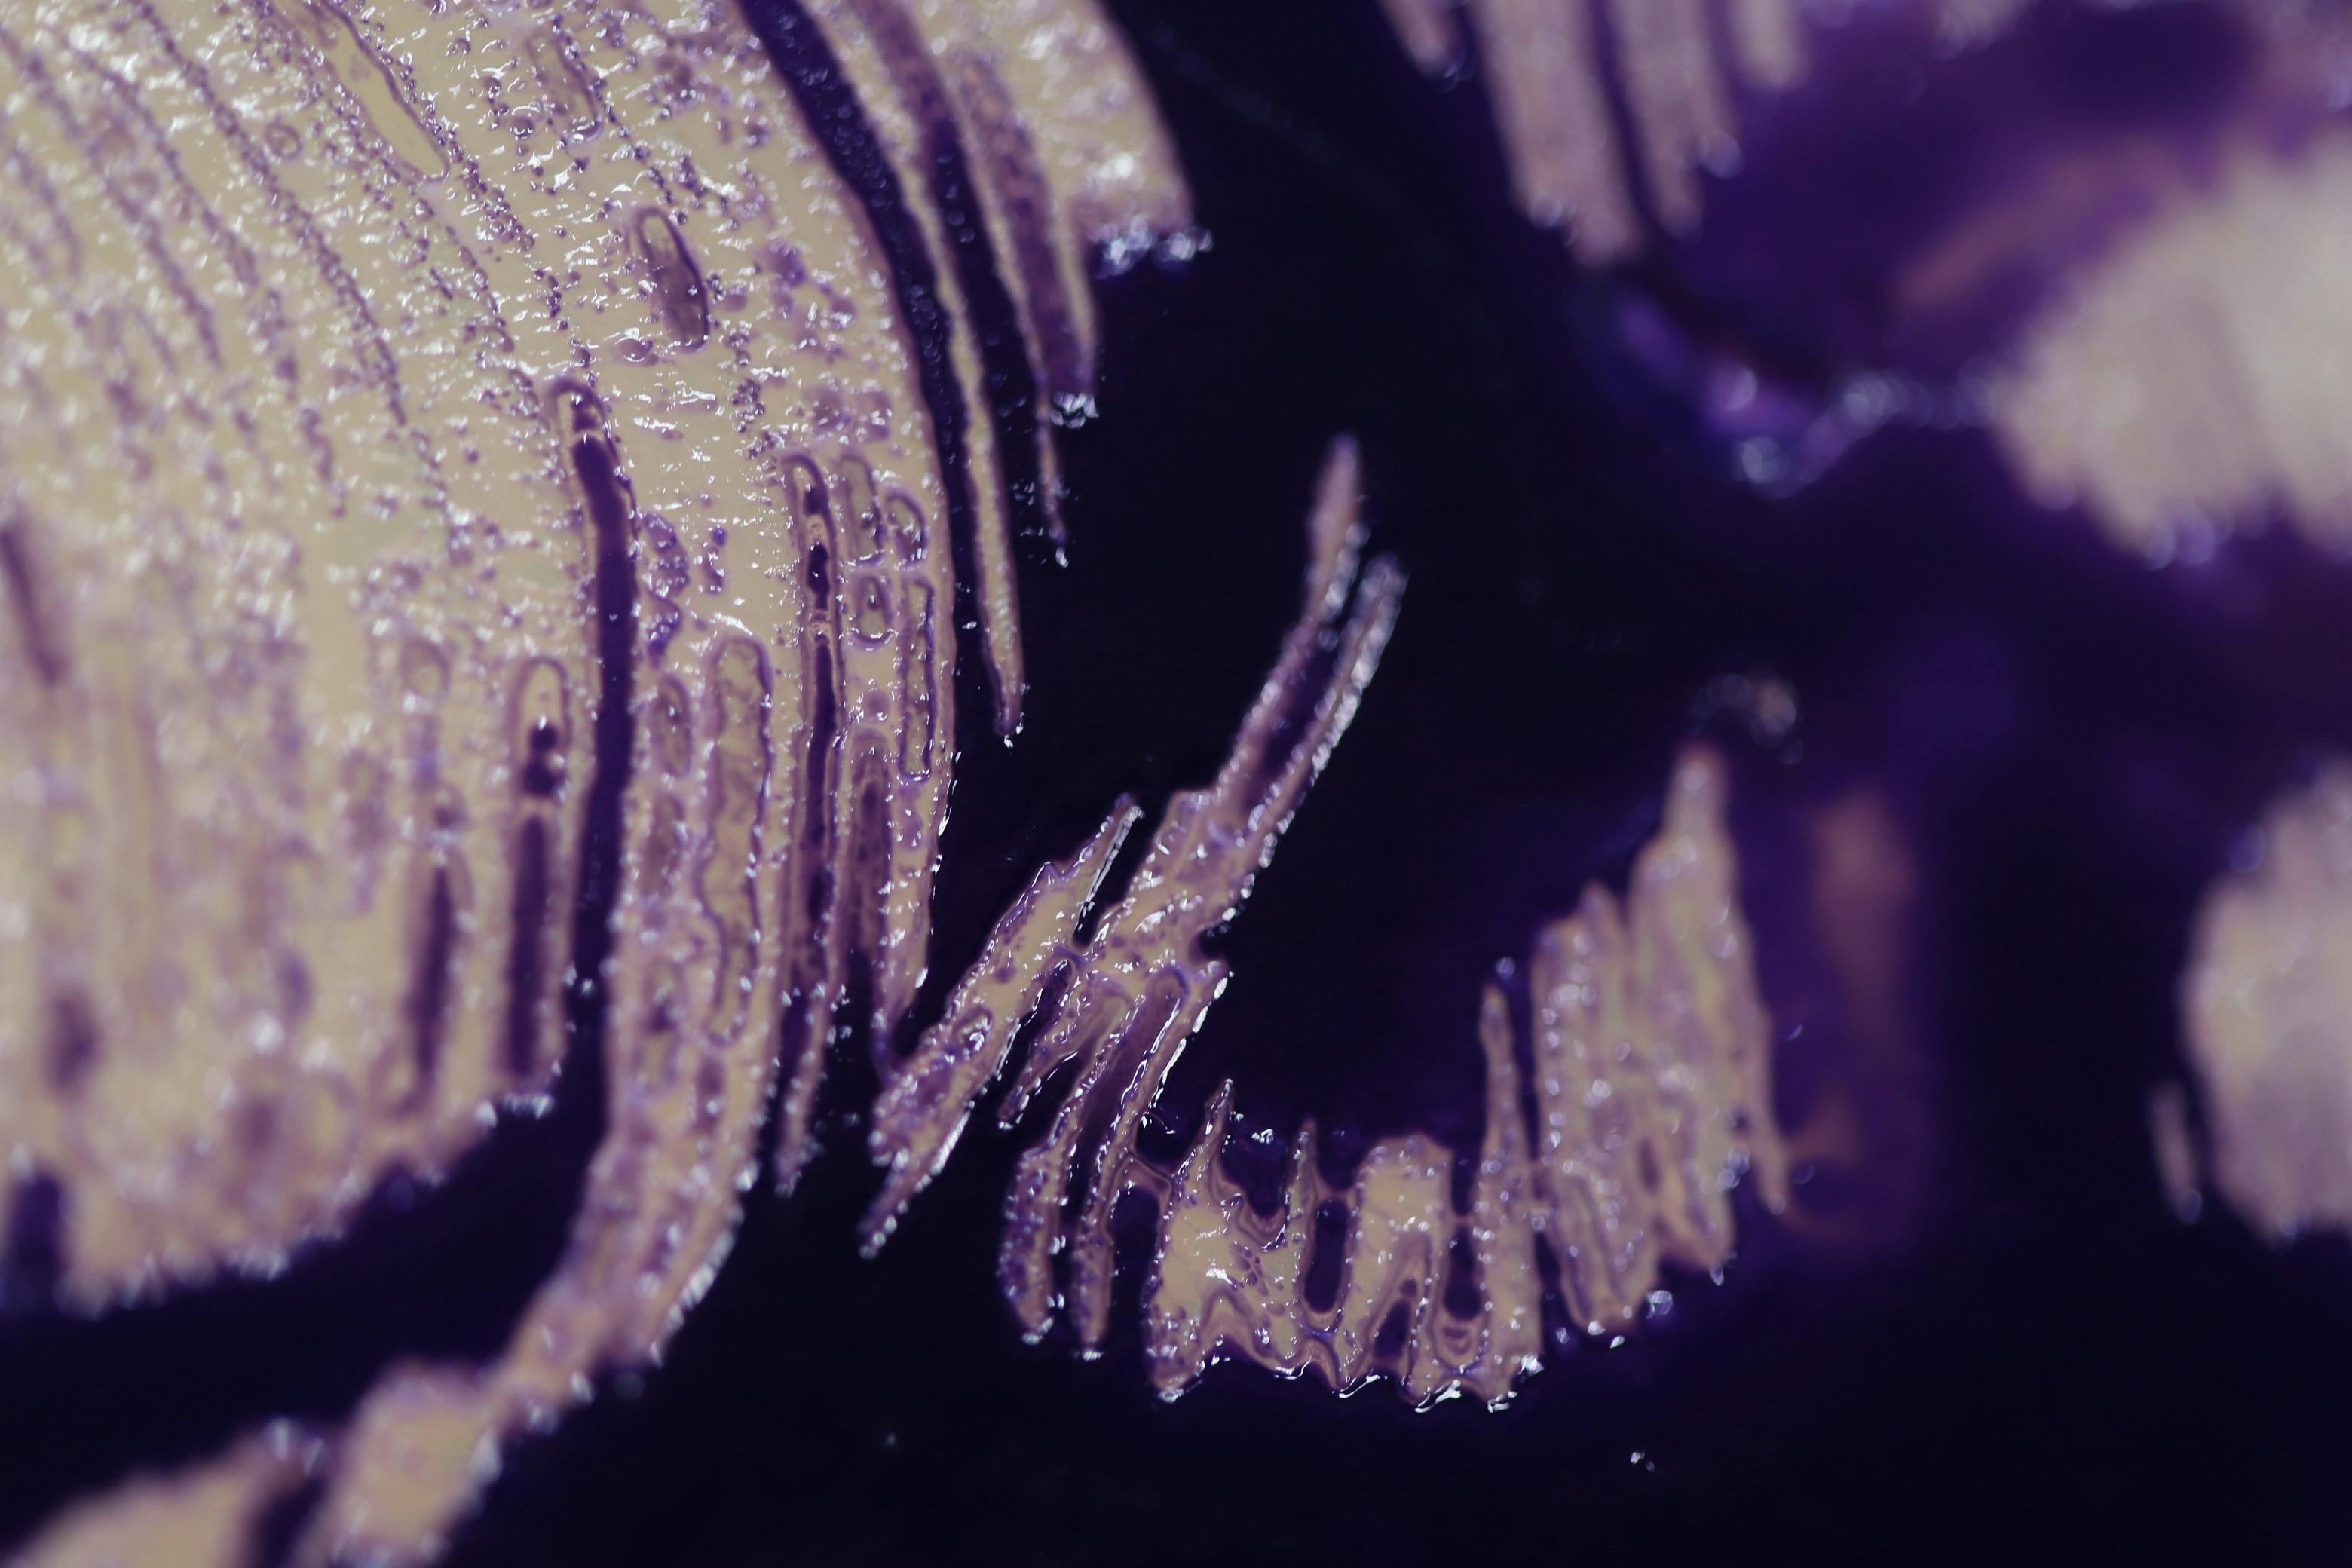
/how-lite-1-is-redefining-sustainability-interview-with-startups-of-the-year-2024-nominee feature image

On This Day in Tech History

The First Outer Solar System Landing Occurred
2005The European Space Agency’s Huygens probe lands on Saturn‘s moon Titan. This was the first landing ever accomplished in the outer solar system.
NSA was reported using spyware on other countries
2014The NY Times reported that the National Security Agency has implanted surveillance conducting spyware in nearly 100,000 computers around the world, but not in the United States.

Net Neutrality took a big hit!
2014A federal appeals court ruled Internet service providers are free to make deals with services like Netflix or Amazon allowing those companies to pay to stream their products to online viewers through a faster, express lane on the web,
311 Stories To Learn About Noonies
January 14, 2024
94 Stories To Learn About Noonies2020
January 14, 2024
Composite Keys: A Guide on How to Handle Them
January 14, 2024
Who even reads HackerNoon?
January 14, 2022
How to Fetch API Data With RTK (Redux-Toolkit)
January 14, 2022
How to Insert Binary Tree in Rust
January 14, 2022
No Sound on Windows 10? Here's the Fix
January 14, 2021
The Case for Stablecoins — 1
January 14, 2019
Great Managers Do One Job Well
January 14, 2019
Founder Interviews: David Darmanin of Hotjar
January 14, 2019
What to Expect When ETH’s Expecting
January 14, 2019
While parents aren’t watching
January 14, 2018
Store of value / Vulnerabilities in store
January 14, 2018
Software is eating the world
January 14, 2017
My First Writing on Bitcoin
January 14, 2017
Tmux productivity!
January 14, 2017
Are You Lucky?
January 14, 2016
The Opportunity State
January 14, 2016
How Smart Leaders Protect Company Data
January 14, 2016
Jonathan Kotthoff: Alumni Success Story
January 14, 2016
For Entrepreneurs
January 14, 2016
Technology will eat us alive.
January 14, 2016
What has become of LinkedIn?
January 14, 2016